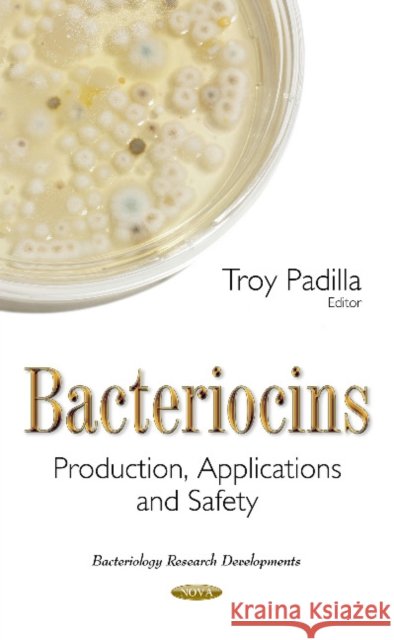
Bacteriocins: Production, Applications & Safety Troy Padilla 9781634844994 Nova Science Publishers Inc - książka

Bacteriocins: Production, Applications & Safety » książka
topmenu
Bacteriocins: Production, Applications & Safety
ISBN-13: 9781634844994 / Angielski / Twarda / 2016 / 140 str.
Kategorie:
Kategorie BISAC:
Wydawca:
Nova Science Publishers Inc
Język:
Angielski
ISBN-13:
9781634844994
Rok wydania:
2016
Dostępne języki:
Angielski
Wydanie:
UK
Ilość stron:
140
Waga:
0.40 kg
Wymiary:
23.023.0 x 15.5
Oprawa:
Twarda
Wolumenów:
01